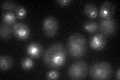

View description
Enoyl reductase that catalyzes the last step in each cycle of very long chain fatty acid elongation, localizes to the ER, highly enriched in a structure marking nuclear-vacuolar junctions, coimmunoprecipitates with elongases Fen1p and Sur4p
Localization:
Intensity:
Fold change:
Significance:
-
C’ GFP library in SD

punctate:ER76.58 -
N' NOP1pr-GFP in SD

ER,punctate170.452 -
N' TEF2pr-mCherry in SD

ER,vacuole354.519 -
N' NATIVEpr-GFP in SD

ER,punctate86.3238 -
N' TEF2pr-VC and Cyto-VN in SD

ER47.9279 -
C’ GFP library in SD+DTT

punctate.ER68.960.9No -
C’ GFP library in SD+H2O2

punctate.ER62.50.81No -
C’ GFP library in Starvation Media
punctate,ER72.210.94No -
C’ GFP library on the background of Pup2-DaMP

punctate:ER -
C’ GFP library on the background of CCT mutant

punctate:ER82.61221.07863No
